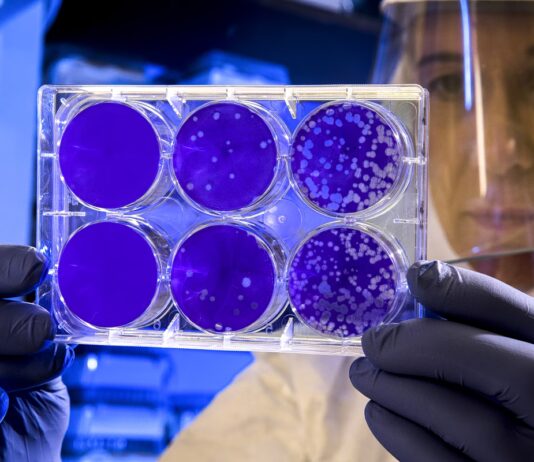

Οι Τάσεις Τώρα
Καιρός: Έρχεται 48ωρη κακοκαιρία με καταιγίδες, χιόνια και ανεμοστρόβιλους
Σύνοψη άρθρου από το Verginanews AI
Σε κλοιό διαδοχικών κυμάτων κακοκαιρίας συνεχίζει να βρίσκεται η χώρα μας, με το νέο χαμηλό βαρομετρικό να χτυπά για 48...
Θεσσαλονίκη: Οριστικό τέλος στην ομηρία της πλατείας Ελευθερίας
Σύνοψη άρθρου από το Verginanews AI
Οριστικό τέλος μπήκε στην ομηρία της ανάπλασης της πλατείας Ελευθερίας, στο κέντρο της Θεσσαλονίκης, και της μετατροπής της σε Πάρκο Μνήμης των...
ΟΙΚΟΝΟΜΙΑ
Δένδιας σε Γαλλίδα υπ. Άμυνας: «Επισπεύδουμε την ανανέωση της ελληνογαλλικής αμυντικής συμφωνίας» (βίντεο)
Σύνοψη άρθρου από το Verginanews AI
Για επίσπευση της ανανέωσης της ελληνογαλλικής αμυντικής συμφωνίας, έκανε λόγο ο υπουργός μετά την συνάντησή του με την...
Βιολάντα: Τι δείχνει η έκθεση του ΤΕΕΜ- Οι τρεις σοβαρές παραλείψεις ασφαλείας που ερευνούν...
Σύνοψη άρθρου από το Verginanews AI
Σοβαρές ελλείψεις ασφαλείας στο εργοστάσιο «Βιολάντα» αποκαλύπτουν τα πρώτα πορίσματα, ενώ ανοιχτό παραμένει το ενδεχόμενο αναβάθμισης των κατηγοριών.
Ιδιαίτερα...
Ελληνίδα Πρέσβειρα στην Ρουμανία: «Προτεραιότητα ο επαναπατρισμός των σορών και η φροντίδα των τραυματιών»
Σύνοψη άρθρου από το Verginanews AI
Σε πλήρη κινητοποίηση βρίσκεται η ελληνική πρεσβεία στο...
Παπαθανάσης: Στο ΕΣΠΑ η ενεργειακή αναβάθμιση του Δημαρχείου Αμαρουσίου, ύψους 3.198 εκατ. ευρώ
Σύνοψη άρθρου από το Verginanews AI
Στο πρόγραμμα του ΕΣΠΑ «Περιβάλλον και...
Μητροπολίτης Φιλόθεος: «Η Εκκλησία πενθεί μαζί με τις οικογένειες των οπαδών του ΠΑΟΚ»
Σύνοψη άρθρου από το Verginanews AI
Ο μητροπολίτης Θεσσαλονίκης Φιλόθεος εκφράζει συλλυπητήρια...
Θεσσαλονίκη: Αγέλη πέντε λύκων κινείται σε Πανόραμα και Θέρμη-Η ανακοίνωση που εξέδωσε η “Καλλιστώ”
Σύνοψη άρθρου από το Verginanews AI
Αναστάτωση έχει προκληθεί το τελευταίο διάστημα...
Παπαθανάσης: Έγκριση Περιφερειακών Προγραμμάτων Ανάπτυξης Ανατολικής Μακεδονίας-Θράκης, Δυτικής Μακεδονίας και Ιωνίων Νήσων στο πλαίσιο...
Σύνοψη άρθρου από το Verginanews AI
Με αποφάσεις του Αναπληρωτή Υπουργού Εθνικής...
Θεσσαλονίκη: Εισαγγελική έρευνα για το ατύχημα με τέσσερις τραυματίες κατά τη σύνδεση αγωγού της...
Σύνοψη άρθρου από το Verginanews AI
Ο προϊστάμενος της Εισαγγελίας Εφετών Θεσσαλονίκης,...